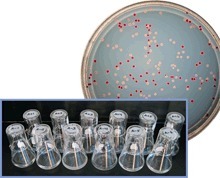

See on
Scoop.it– AnnBot

I’ve been thinking a lot about the long-term evolution experiment (LTEE) with E. coli lately – even more than usual. One impetus has been the paper by Mike Wiser, Noah Ribeck, and me that appeared…
See on Scoop.it – AnnBot I’ve been thinking a lot about the long-term evolution experiment (LTEE) with E. coli lately – even more than usual. One impetus has been the paper by Mike Wiser, Noah Ribeck, and me that appeared… See on telliamedrevisited.wordpress.com
Source: https://www.botany.one/fifty-thousand-squared/
See on
Scoop.it– AnnBot
I’ve been thinking a lot about the long-term evolution experiment (LTEE) with E. coli lately – even more than usual. One impetus has been the paper by Mike Wiser, Noah Ribeck, and me that appeared…
